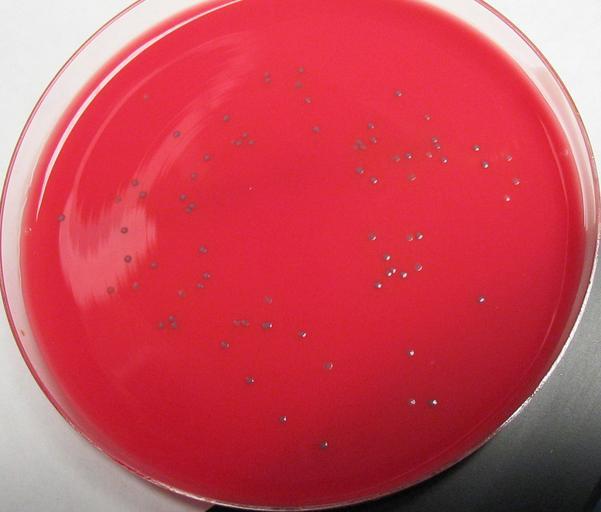

MAKE A MEME
View Large Image
| View Original: | Smooth L'mono.jpg (1288x1098) | |||
| Download: | Original | Medium | Small | Thumb |
| Courtesy of: | commons.wikimedia.org | More Like This | ||
| Keywords: Smooth L'mono.jpg Listeria monocytogenes grown on Bio-Rad RAPID'L Mono® Agar Own 2003-10-7 James folsom 00 59 15 January 2007 UTC Listeria monocytogenes | ||||